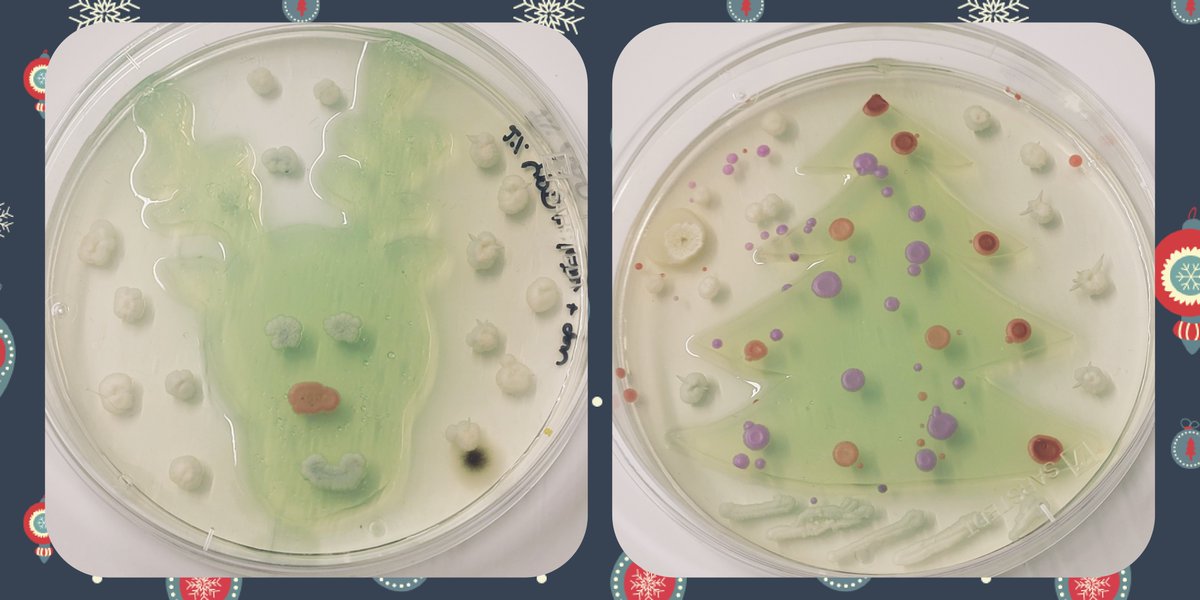
Merry Christmas from our research group with some of our yeast friends growing in holiday mood.

Attila Csikasz-Nagy
@csikasznagy
Computational systems biologists at King's College London (UK) and Pazmany University (HU), CEO at Cytocast
ID: 1920215137
http://csikasznagylab.org/ 30-09-2013 14:02:51
449 Tweet
390 Followers
374 Following

Come join us! I’m looking for 2 #synbio postdocs to join my group as soon as possible to work on synthetic genomics. Eukaryote/Yeast experience desired. Posts can be at Imperial College London London or Wellcome Sanger Institute Cambridge depending on applicant preference. Please RT.


Recognising a need to communicate the science behind #COVID19 vaccines in an accessible way, School of Basic & Medical Biosciences Senior Lecturer Dr Claudia Linker spearheaded the creation of this valuable video. Read more about the process here: bit.ly/3hb9l7v youtube.com/watch?v=65gyCC…

Amazing job by Rosa Hernansaiz! It was an honour to supervise her with Luca Cardelli! This is a result of a great collaboration with Laszlo G. Nagy and Csenge Földi from his lab.

How to identify the parameters of a model by fitting to bifurcation points? Suggested answer by Grisha Zepp Neil Dalchau and me just released arxiv.org/abs/2106.04243







Congratulations to Grisha Zepp for defending his PhD! Many thanks to Ruth Baker and SwainLab for the examination and Neil Dalchau for co-supervising Grisha! A great scientist emerging!


#InterfaceFocus has recently published Part I of a new issue which brings together articles on time-keeping & decision-making in living cells: ow.ly/ozJC50IOIag Attila Csikasz-Nagy PPCU Université libre de Bruxelles KAIST 수리과학과 The Francis Crick Institute Max Delbrück Center FUBiS



Check out Part I of the latest #InterfaceFocus issue which brings together articles on time-keeping & decision-making in living cells: royalsocietypublishing.org/toc/rsfs/2022/… Attila Csikasz-Nagy PPCU Université libre de Bruxelles KAIST 수리과학과 The Francis Crick Institute Max Delbrück Center FUBiS


Have you read our latest #InterfaceFocus issue? Bringing together articles on time-keeping in living cells, it has a specific emphasis on circadian clocks: ow.ly/irqf50IVLp0 VT Biology PPCU Université libre de Bruxelles KAIST 수리과학과 The Francis Crick Institute Max Delbrück Center


(2/4) A study by Attila Csikasz-Nagy lab finds that the reversed action of the kinase-phosphatase pair Wee1 and Cdc25 adds a checkpoint to the cell cycle, and this twist in the kinase-phosphatase interaction helps establish a stable G2 phase go.nature.com/3Fpz1t0


Paper by suchana chakravarty with Chris Hong of University of Cincinnati is out npj Journals #SystemsBiology on the analysis of temperature compensation and robustness of minimal #circadian clock models rdcu.be/c5n2v



Really proud of my yeast systems biology group itk.ppke.hu/en/systems-bio… for publishing our first experiment + model paper based on in-house experiments to explain how yeast colonies grow. Read our Communications Biology paper at rdcu.be/dGaKn


Integrative analysis of yeast colony growth Communications Biology from Attila Csikasz-Nagy nature.com/articles/s4200…